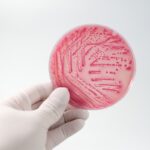

Confirman un caso de Síndrome Urémico Hemolítico en Hernando
octubre 30, 2025
Tancacha: Cerraron un punto de venta de drogas y detuvieron a una mujer
octubre 31, 2025Personal policial llevó adelante operativos de control vehicular en calle Sarmiento, donde se procedió al secuestro de dos motocicletas cuyos conductores no contaban con la documentación obligatoria para circular.
Desde la Comisaría de Distrito Hernando, dependiente de la Departamental Tercero Arriba, informaron que durante la tarde del jueves se realizaron controles preventivos en distintos puntos de la ciudad.
A las 18:30 horas, en calle Sarmiento, efectivos procedieron al secuestro de una motocicleta marca Corven 110 c.c., conducida por un joven de 23 años de edad, quien no contaba con la documentación obligatoria exigida por ley.
Minutos más tarde, a las 19:00 horas, en la misma arteria, se efectuó otro control que derivó en el secuestro de una motocicleta marca Rouser NS200, sin dominio colocado, también conducida por un joven de 23 años que carecía de la documentación necesaria para circular.
Ambos procedimientos fueron realizados en el marco de lo establecido por el Código de Convivencia Ciudadana de la Provincia de Córdoba (Ley 10.326), quedando los rodados a disposición de la autoridad competente.




